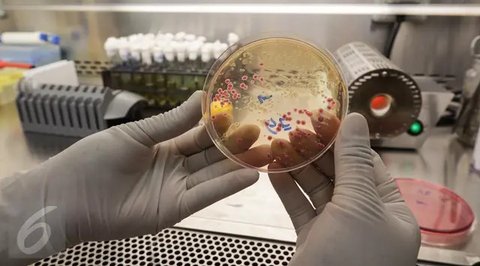
Tahun 2025 menjadi sangat istimewa bagi OMEGA karena menandai 60 tahun sejak Speedmaster resmi dikualifikasi oleh NASA untuk semua misi luar angkasa. (foto/dok: OMEGA)

NASA 'Cari Penyakit' Bakteri Mematikan Dibawa ke Luar Angkasa
Misi terbaru NASA ke Stasiun Luar Angkasa Internasional bukanlah sebuah fiksi ilmiah.

NASA kembali melakukan peluncuran misi ilmiah yang cukup menarik ke Stasiun Luar Angkasa Internasional (ISS).
Kali ini, misi tersebut tidak hanya mengangkut astronot, tetapi juga beberapa strain bakteri yang dapat menyebabkan penyakit serius.
Dalam misi Crew-11 ini, para ilmuwan mengirimkan strain bakteri berbahaya, termasuk E. coli, patogen penyebab tifoid, dan Salmonella, untuk dianalisis lebih lanjut di luar angkasa.
Tujuan dari eksperimen ini adalah untuk memahami bagaimana bakteri berkembang dan mengalami mutasi dalam kondisi tanpa gravitasi, serta untuk mengetahui apakah lingkungan ekstrem di ISS dapat mempengaruhi potensi resistansi terhadap antibiotik.
Mengutip Engadget, Kamis (7/8), penelitian ini merupakan hasil kolaborasi antara Sheba Medical Center dari Israel dan perusahaan teknologi luar angkasa asal Amerika Serikat, Space Tango.
Melalui proyek ini, para ilmuwan berharap dapat menemukan jawaban yang signifikan terkait penyebaran penyakit dan ketahanan bakteri, baik di luar angkasa maupun di Bumi.
Penelitian ini diharapkan dapat memberikan wawasan baru yang berguna dalam pengembangan strategi untuk mengatasi masalah kesehatan yang disebabkan oleh bakteri berbahaya.
Bakteri dibiarkan berkembang di ISS

Eksperimen yang dilaksanakan di Stasiun Luar Angkasa Internasional (ISS) bukanlah untuk menakut-nakuti, tetapi sepenuhnya bertujuan untuk kepentingan ilmiah dan kesehatan.
Para ilmuwan berusaha memahami bagaimana perilaku bakteri berubah dalam kondisi tanpa gravitasi.
Bakteri yang diujikan, seperti E. coli dan bakteri penyebab tifoid, akan diinkubasi dalam lingkungan mikrogravitasi untuk mengevaluasi apakah kondisi ekstrem ini memengaruhi pertumbuhan atau mutasi mereka.
Setelah inkubasi di luar angkasa selesai, bakteri tersebut akan dikembalikan ke Bumi. Peneliti akan membandingkan bakteri tersebut dengan strain yang tumbuh di laboratorium dalam kondisi normal.
Tujuan utama dari penelitian ini adalah untuk mengetahui apakah lingkungan luar angkasa dapat mempercepat atau justru menghambat resistansi terhadap antibiotik.
Hal ini sangat penting, mengingat astronot memiliki risiko tinggi terhadap infeksi selama misi mereka akibat kombinasi stres, paparan radiasi, dan sistem kekebalan tubuh yang melemah akibat perubahan gravitasi.
Penelitian ini berpotensi membuka wawasan baru tentang perlindungan kesehatan di luar angkasa dan mengungkap kemungkinan solusi medis yang dapat diterapkan di Bumi.
Peta genetik bakteri di luar angkasa sangat menarik diteliti
Eksperimen ini memberikan kesempatan baru bagi perkembangan mikrobiologi. Untuk pertama kalinya, para ilmuwan akan melakukan pemetaan ekspresi genetik bakteri patogen secara sistematis dan molekuler di luar angkasa.
Hal ini diungkapkan oleh Ohad Gal-Mor, yang merupakan kepala Laboratorium Penelitian Penyakit Menular di Sheba Medical Center dan salah satu tokoh kunci dalam penelitian ini.
Sebelumnya, Sheba telah melaksanakan simulasi eksperimen dalam lingkungan buatan yang meniru kondisi di luar angkasa.
Hasil dari simulasi tersebut cukup mengejutkan, di mana bakteri menunjukkan penurunan kemampuan untuk membentuk resistansi terhadap antibiotik.
Namun, eksperimen yang saat ini dilakukan di ISS merupakan yang pertama dilaksanakan secara langsung di luar angkasa, bukan dalam simulasi.
Langkah ini menjadi tonggak penting dalam penelitian mikrobiologi antariksa. Jika eksperimen ini berhasil, para peneliti akan memperoleh pemahaman yang lebih mendalam mengenai bagaimana kondisi luar angkasa memengaruhi sifat genetik bakteri.
Temuan ini tidak hanya akan berkontribusi pada kesehatan kru luar angkasa, tetapi juga dapat memberikan solusi jangka panjang terhadap ancaman superbug di Bumi.
Bantu perangi superbug di dunia

Penelitian mengenai bakteri di luar angkasa bukanlah hal yang baru. Pada tahun 2017, sekelompok ilmuwan dari University of Houston telah melakukan eksperimen untuk mengamati pertumbuhan E. coli dalam kondisi yang menyerupai mikrogravitasi.
Selain itu, NASA juga pernah meluncurkan proyek yang meminta para astronot di Stasiun Luar Angkasa Internasional (ISS) untuk mengambil sampel bakteri dari berbagai permukaan di dalam stasiun tersebut.
Tujuan utama dari proyek ini adalah untuk memetakan keberadaan bakteri yang berpotensi menjadi superbug, yaitu bakteri yang memiliki ketahanan terhadap berbagai jenis antibiotik.
Mengingat ancaman resistansi antibiotik yang terus meningkat di seluruh dunia, penelitian semacam ini menjadi semakin krusial.
Data yang diperoleh dari luar angkasa dapat memberikan wawasan tentang bagaimana mutasi dan adaptasi bakteri terjadi dalam lingkungan yang ekstrem.
Jika para ilmuwan dapat memahami proses evolusi bakteri di ruang angkasa, mereka mungkin akan menemukan strategi medis baru untuk mengatasi infeksi yang sulit diobati di Bumi.
Dengan demikian, penelitian ini tidak hanya berkontribusi terhadap ilmu pengetahuan, tetapi juga memiliki implikasi yang signifikan bagi kesehatan manusia di masa depan.

























:strip_icc():format(webp)/kly-media-production/medias/8264046/original/011687600_1782061641-unnamed__20_.jpg)
:strip_icc():format(webp)/kly-media-production/medias/8261358/original/022817400_1781697976-WhatsApp_Image_2026-06-17_at_18.59.09.jpeg)
:strip_icc():format(webp)/kly-media-production/medias/8263960/original/010628400_1782037170-20250508_121105.jpg)
:strip_icc():format(webp)/kly-media-production/medias/5516574/original/086754200_1772331275-unnamed__60_.jpg)
:strip_icc():format(webp)/kly-media-production/medias/5536975/original/096471500_1774370290-LRT_Libur.jpeg)
:strip_icc():format(webp)/kly-media-production/medias/8263910/original/058008400_1782032116-367472.jpg)




















